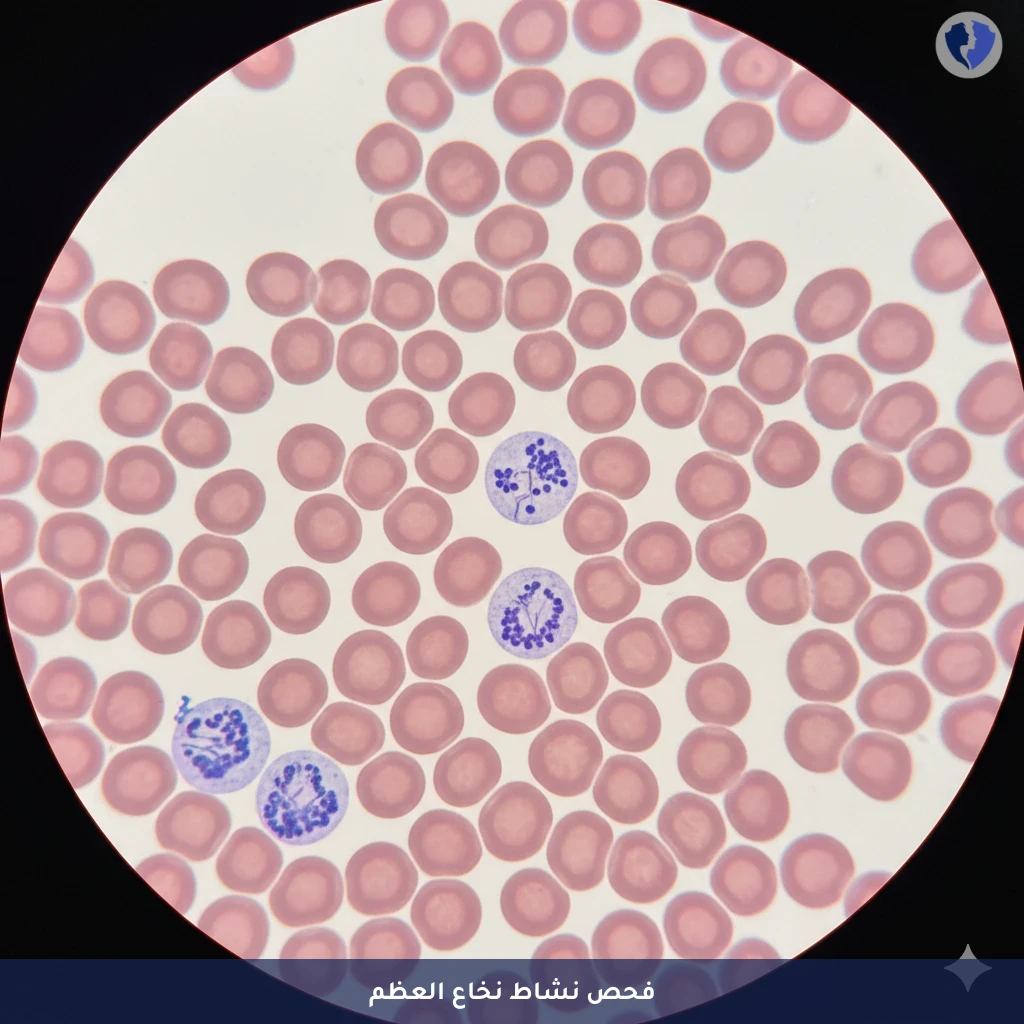
فحص الخلايا الشبكية بالدم - تحليل عد الخلايا الشبكية (Reticulocytes)

تفاصيل الخدمة
فحص الخلايا الشبكية بالدم - تحليل عد الخلايا الشبكية (Reticulocytes)
فحص دموي كمي يقيس نسبة أو العدد المطلق للخلايا الشبكية (Reticulocytes) في الدم المحيطي. الخلايا الشبكية هي خلايا دم حمراء غير ناضجة حديثة التصنيع، تم إطلاقها من نخاع العظم إلى مجرى الدم قبل أن تفقد النواة وتحتفظ ببقايا عضيات (شبكة من الحمض النووي الريبي والريبوسومات) يمكن صبغتها وتعديدها مجهرياً أو باستخدام محللات دموية آلية. تعكس نسبة الخلايا الشبكية نشاط تصنيع كريات الدم الحمراء في نخاع العظم (Erythropoiesis).